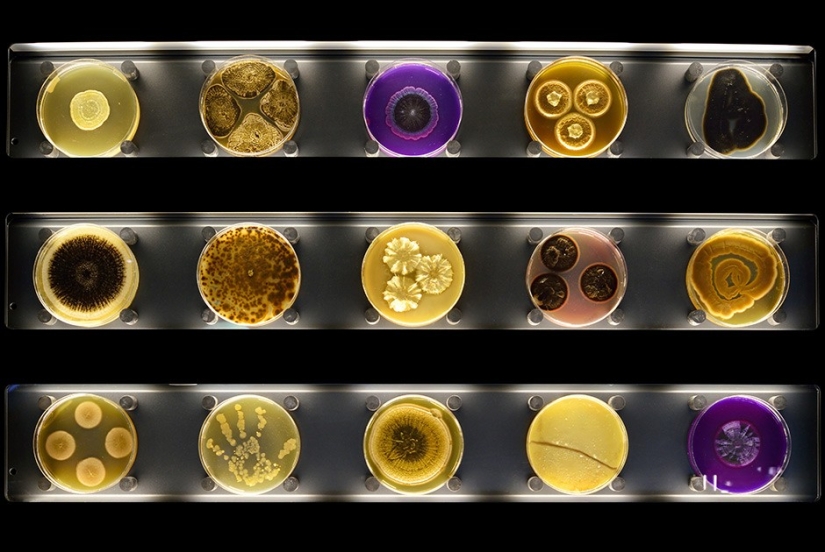

With myopia - into Micropia
Categories: Microworld
By Pictolic https://mail.pictolic.com/article/with-myopia-into-micropia.htmlMicropia is the world's first interactive microbe zoo. It is located in Amsterdam, next to the Artis City Zoo. Here visitors can get acquainted with the life of organisms that are too small to see them with the naked eye. We offer to take a tour of Micropia.


In the zoo, you can scan your own body in order to detect your own germs.
Colonies of microbes living on human fingers are strictly individual (two people have no more than 13% of the species of such bacteria in common), which is used in the work of criminologists.
The exhibition has a stand with 150 Petri dishes containing various microorganisms.
The Petri dish was invented in 1877 and received the name of its creator — the German bacteriologist Julius Richard Petri, assistant to the equally famous scientist Robert Koch.

Diatoms (Triceratium sp.) in the process of photosynthesis generate the main amount of oxygen contained in the Earth's atmosphere.
During the mission of the Curiosity rover, scientists found that previously there were favorable living conditions for simple microorganisms on Mars.

Cultures of microorganisms are grown in the Micropia laboratory.
Microbiomes (communities of microbes living in a separate organism) are closely related to the house where a person (and his family) lives. When people move, their unique microbiological "aura" moves with them.

In the zoo, you can see 3D landscapes of microbe habitats.
At least 3,931 operational taxonomic units (species and groups of species) of microorganisms are found in the waters of Lake Willans (Antarctica).

The Pilobolaceae family are fungi that reproduce in the excrement of herbivorous animals.
Pilobolus kleinii, decomposing the manure of herbivorous animals, shoot their spores with a record acceleration for nature — 180 thousand g, that is, 180 thousand times the acceleration of free fall.

Couples in love can kiss and find out how many bacteria they passed on to each other during the kiss.
More than 700 types of microorganisms constantly live in the oral cavity of each person: various kinds of bacteria, protozoa, fungus, viruses.

Noctiluca scintillans (Noctiluca scintillans) cause the glow of sea waves in the dark.
Noctuids — armored flagellates - account for half of the total weight of the Black Sea zooplankton. It is because of them that the waters of the Black Sea glow in autumn.

Glass models of various viruses are demonstrated in Micropia. In the photo, a laboratory employee holds an HIV model, and the famous Ebola virus is visible on the right.
The monkey immunodeficiency virus (Simian immunodeficiency virus, SIV), carried by chimpanzees from the southeastern part of Cameroon, is closest to HIV group M - the cause of more than 90% of human infections.

"Our goal is to show visitors that everything in nature is interconnected and that microbes are the most important part of these connections," says Haig Balyan, Director of Micropia.
The body of an adult weighing about 90 kilograms contains from 1 to 2.7 kilograms of microorganisms.

Tardigrades are a species of microscopic invertebrates close to arthropods.
In 2008, it was found that slow walkers are able to survive even in outer space.

Radiolaria is a single-celled planktonic organism.
Radiolarians, or ray-finders, live mainly in warm oceanic waters. The mechanism of their nutrition is practically not studied.

Spiral staircases in Micropia reproduce the structure of DNA.
In 1953, James Watson and Francis Crick proposed a two-spiral model of the DNA molecule. "And we have just discovered the secret of life!" - this is how they reported their scientific achievement.
Keywords: Amsterdam | Zoo | Microbes
Post News ArticleRecent articles
Sometimes you see a tattoo on a person and think: "Why did he do it at all?". A familiar feeling? If you have never experienced it, ...
Taxi ride like a lottery — you never know if you will pull the winning ticket. Even the official services like Uber does not ...
Related articles
No one will argue with the fact that Russia — unique country, where it can happen that it is impossible in any other country. ...
Bearded men are carriers of more germs than dogs. This conclusion was reached by Swiss scientists after a comparative study of ...
Did you know that your phone — a real hotbed of germs? According to numerous studies, the surface of most cell dirtier than ...

Finnish photographer Juha Tanhua has shot an unusual series of "space photos". Astrophotographic images of stars, galaxies and ...